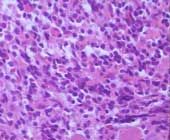
消化道出血

簡介
所屬部位:腹部就診科室:消化內科,外科,胃腸科
症狀體徵:嘔血與黑便,腹痛
病因
消化道出血可因消化道本身的炎症、機械性損傷、血管病變、腫瘤等因素引起,也可因鄰近器官的病變和全身性疾病累及消化道所致。
(一)上消化道出血的病因
1.食管疾病食管炎(反流性食管炎、食管憩室炎)、食管癌、食管潰瘍、食管賁門黏膜撕裂症、器械檢查或異物引起損傷、放射性損傷、強酸和強鹼引起化學性損傷。
 十二指腸炎
十二指腸炎3.胃腸吻合術後的空腸潰瘍和吻合口潰瘍。
4.門靜脈高壓,食管胃底靜脈曲線破裂出血、門脈高壓性胃病肝硬化、門靜脈炎或血栓形成的門靜脈阻塞、肝靜脈阻塞(Budd-Chiari綜合徵)。
5.上消化道鄰近器官或組織的疾病
(1)膽道出血:膽管或膽囊結石、膽道蛔蟲病、膽囊或膽管病、肝癌、肝膿腫或肝血管病變破裂。
(3)胸或腹主動脈瘤破入消化道。
(4)縱隔腫瘤或膿腫破入食管。
6.全身性疾病在胃腸道表現出血
白血病
白血病(2)尿毒症。
(3)結締組織病:血管炎。
(4)應激性潰瘍:嚴重感染、手術、創傷、休克、腎上腺糖皮質激素治療及某些疾病引起的應激狀態,如腦血管意外,肺源性心臟病、重症心力衰竭等。
(5)急性感染性疾病:流行性出血熱、鉤端螺鏇體病。
(二)下消化道出血病因
2.直腸疾病直腸的損傷、非特異性直腸炎、結核性直腸炎、直腸腫瘤、直腸類癌、鄰近惡性腫瘤或膿腫侵入直腸。
3.結腸疾病細菌性痢疾、阿米巴痢疾、慢性非特異性潰瘍性結腸炎、憩室、息肉、癌腫和血管畸形。
此外肝癌晚期門靜脈高壓而導致的食管及胃底靜脈曲張,並且由於肝癌晚期出現的肝功能受損、凝血功能異常等因素,而易發生消化道大出血。
症狀
(一)上消化道大量出血的早期識別若上消化道出血引起的急性周圍循環衰竭徵象的出現先於嘔血和黑糞,就必須與中毒性休克、過敏性休克、心源性休克或急性出血壞死性胰腺炎,以及子宮異位妊娠破裂、自發性或創傷性脾破裂、動脈瘤破裂等其他病因引起的出血性休克相鑑別。有時尚須進行上消化道內鏡檢查和直腸指檢,藉以發現尚未嘔出或便出的血液,而使診斷得到及早確立。
 消化道出血
消化道出血(二)出血量的估計上消化道出血量達到約20ml時,糞便匿血(愈創木脂)試驗可呈現陽性反應。當出血量達50~70ml以上,可表現為黑糞。嚴重性出血指3小時內需輸箅1500ml才能糾正其休克。嚴重性出血性質又可分為大量出血(massivebleeding)即指每小時需輸血300ml才能穩定其血壓者;最大量出血(majorhemorrhage)即指經輸血1000ml後血紅蛋白仍下降到10g/dl以下者。持續性出血指在24小時之內的2次胃鏡所見均為活動性出血,出血持續在60小時以上,需輸箅3000ml才能穩定循環者。再發性出血指2次出血的時間距離至少在1~7天。如果出血量不超過400ml,由於輕度的血容量減少可很快被組織過500ml,失血又較快時,患者可有頭昏、乏力、心動過速和血壓偏低等表現,隨出血量增加,症狀更加顯著,甚至引起出血性休克。
對於上消化道出血量的估計,主要根據血容量減少所致周圍循環衰竭的臨床表現,特別是對血壓、脈搏的動態觀察。根據病人的血紅細胞計數,血紅蛋白及血細胞壓積測定,也可估計失血的程度。
(三)出血的病因和部位的診斷
 黃疸
黃疸2.特殊診斷方法近年來道出血的臨床研究有了很大的進展,除沿用傳統方法一-X線鋇餐或久灌檢查之外,內鏡檢查已普遍套用,在診斷基礎上又發展了血治療。
(1)X線鋇劑檢查:僅適用於出血已停止和病情穩定的患者,其對急性消化道出血病因診斷的陽性率不高。
(2)內鏡檢查
(3)血管造影
(4)放射性核素顯像:近年套用放射性核素顯像檢查法來發現活動性出血的部位,其方法是靜脈注射99m鎝膠體後作腹部掃描,以探測標記物從血管外溢的證據,可直到初步的定向作用。
消化道出血的臨床表現取決於出血病變的性質、部位、失血量與速度,與患者的年齡、心腎功能等全身情況也有關係。
(一)出血方式急性大量出血多數表現為嘔血;慢性小量出血則以糞便潛血陽性表現;出血部們在空腸曲氏韌帶以上時,臨床表現為嘔血,如出血後血液在胃內瀦留時間較久,因經胃酸作用變成酸性血紅蛋白而呈咖啡色。如出血速度快而出血量又多。嘔血的顏色是鮮紅色。黑糞或柏油樣糞便表示出血部位在止胃腸道,但如十二指腸部位病變的出血速度過快時,在腸道停留時間短,糞便顏色會變成紫紅色。右半結腸出血時,糞便顏色為鮮紅色。在空間迴腸及右半結腸病變引起小量滲血時,也可有黑糞。
(二)失血性周圍循環衰竭上消化道大量出血導致急性周圍循環衰竭。失血量達大,出血不止或治療不及時可引起機體的組織血液灌注減少和細胞缺氧。進而可因缺氧、代謝性酸中毒和代謝產物的蓄積,造成周圍血管擴張,毛細血管廣泛受損,以致大量體液淤滯於腹腔骨髒與周圍組織,使有效血容量銳減,嚴重地影響心、腦、腎的血液供應,終於形成不可逆轉的休克,導致死亡。
 冠心病
冠心病(三)氮質血症可分為腸原性、腎性和腎前性氮質血症3種。腸源性氮質血症指在大量上消化道出血後,血液蛋白的分解產物的腸道被吸收,以致血中氮質升高。腎前性氮質血症是由於失血性周圍循環衰竭造成腎血流暫時性減少,腎小球濾過率和腎排泄功能降低,以致氮質貯留。在糾正低血壓、休克後,血中尿素氮可迅速降至正常。腎性氮質血症是由於嚴重而持久的休克造成腎小管壞死(急性腎功能衰竭),或失血更加重了原有腎病的腎臟損害。臨床上可出現尿少或無尿。在出血停止的情況下,氮質血症往往持續4天以上,經過補足血容量、糾正休克而血尿素氮不能至正常。
(四)發熱大量出血後,多數病人在24小時內常出現低熱。發熱的原因可能由於血容量減少、貧血、周圍循環衰竭、血分解蛋白的吸收等因素導致體溫調節中樞的功能障礙。分析發熱原因時要注意尋找其他因素,例如有無並發肺炎等。
(五)出血後的代償功能當消化道出血量超過血容量的1/4時,心排出量和舒張期血壓明顯下降。此時體內相應地釋放了大量幾茶酚胺,增加周圍循環阻力和心脈率,以維持各個器官血液灌注量。除了心血管反應外,激素分泌、造血系統也相應地代償。醛固酮和垂體後葉素分泌增加,儘量減少組織間水分的丟失,以恢復和維持血容量。如仍不能代償就會刺激造血系統,血細胞增殖活躍,紅細胞和網織細胞增多。
檢查
 內鏡
內鏡(1)X線鋇劑檢查:僅適用於出血已停止和病情穩定的患者其對急性消化道出血病因診斷的陽性率不高;
(2)內鏡檢查;
(3)血管造影;
(4)放射性核素顯像:近年套用放射性核素顯像檢查法來發現活動性出血的部位其方法是靜脈注射m鎝膠體後作腹部掃描以探測標記物從血管外溢的證據可直到初步的定向作用。
h2>鑑別 鐵劑
鐵劑(1)鼻、咽喉、口腔出血;
(2)咯血;
(3)藥物、進食引起的黑糞:如動物血、炭粉、鐵劑、鉍劑、中藥等。
併發症
治療
 抗生素
抗生素(二)補充血容量當血紅蛋白低於9g/dl,收縮血壓低於12kPa(90mmHg)時,應立即輸入足夠量的全血。對肝硬化站靜脈高壓的患者要提防因輸血而增加門靜脈壓力激發再出血的可能性。要避免輸血、輸液量過多而引起急性肺水腫或誘發再次出血。
(三)上消化道大量出血的止血處理
1.胃內降溫通過胃管以10~14℃冰水反覆灌洗胃腔而使胃降溫。從而可使其血管收縮、血流減少並可使胃分泌和消化受到抑制。出血部位纖維蛋白溶解酶活力減弱,從而達到止血目的。
2.口服止血劑消化性潰瘍的出血是黏膜病變出血,採用血管收縮劑如去甲腎上腺素8mg加於冰鹽水150ml分次口服,可使出血的小動脈強烈收縮而止血。此法不主張在老年人使用。
3.抑制胃酸分泌和保護胃黏膜H2受體拮抗劑如甲氰咪胍因抑制胃酸提高胃內pH的作用,從而減少H+反彌散,促進止血,對應激性潰瘍和急性胃黏膜病變出血的防治有良好作用。近年來作用於質子泵的制酸劑奧美拉唑,是一種H+、K+ATP酶的阻滯劑,大量出血時可靜脈注射,一次40mg。
4.內鏡直視下止血局部噴灑5%Monsell液(鹼式硫酸鐵溶液),其止血機制在於可使局部胃壁痙攣,出血周圍血管發生收縮,並有促使血液凝固的作用,從而達到止血目的。內鏡直視下高頻電灼血管止血適用於持續性出血者。由於電凝止血不易精確凝固出血點,對出血面直接接觸可引起暫時性出血。近年已廣泛開展內鏡下雷射治療,使組織蛋白凝固,小血管收縮閉合,立即直到機械性血管閉塞或血管內血栓形成的作用。
5.食管靜脈曲張出血的非外科手術治療
(1)氣囊壓迫:是一種有效的,但僅是暫時控制出血的非手術治療方法。半個世紀以來,此方法一直是治療食管靜脈曲張大出血的首選方法,近期止血率90%。三腔管壓迫止血的併發症有:①呼吸道阻塞和窒息;②食管壁缺血、壞死、破裂;③吸入性肺炎。最近幾年,對氣囊進行了改良,在管腔中央的孔道內,可以通過一根細徑的纖維內鏡,這樣就可以直接觀察靜脈曲張出血及壓迫止血的情況。
 奧曲肽
奧曲肽(四)下消化道大量出血的處理基本措施是輸血,輸液,糾正血容量不足引起的休克。多面手儘可能排除上消化道出血的可能,再針對下消化道出血的定位及病因診斷而作出如表1所示的相應治療。
 下消化道出血處理步驟
下消化道出血處理步驟內鏡下止血治療是下消化道出血的道選方法。局部噴灑5%孟氏液、去甲腎上腺素、凝血酶複合物。也可作電凝、雷射治療。
(五)手術處理
1.食管胃底靜脈曲張出血採取非手術治療如輸血、藥物止血、三腔客、硬化劑及栓塞仍不能控制出血者,應作緊急靜脈曲張結紮術,此種方法雖有止血效果,但復發出血率較高。如能同時作脾腎靜脈分流手術可減少復發率。其他手術如門奇靜脈斷流術、H形腸系膜上靜脈下腔靜脈分流術、脾腔靜脈分流術等也在臨床套用中。擇期門腔分流術的手術死亡率低,有預防性意義。由嚴重肝硬化引起者亦可考慮肝移植術。
2.潰瘍病出血當上消化道持續出血超過48小時仍不能停止;24小時內輸血1500ml仍不能糾正血容量、血壓不穩定;保守治療期間發生再出血者;內鏡下發現有動脈活動出血等情況,死亡率高達30%,應儘早外科手術。
<預防
(1)積極治療原發性疾病,如食管炎症、胃潰瘍、慢性肝炎、慢性腎炎,減少出血機會。
(2)慢性病患者,如身體虛弱,常服維生素C,以及大補氣血之中藥,以提高機體適應能力
(3)生活要有規律,避免過度勞累,睡眠應充足,避免情緒緊張,保持情緒穩定

